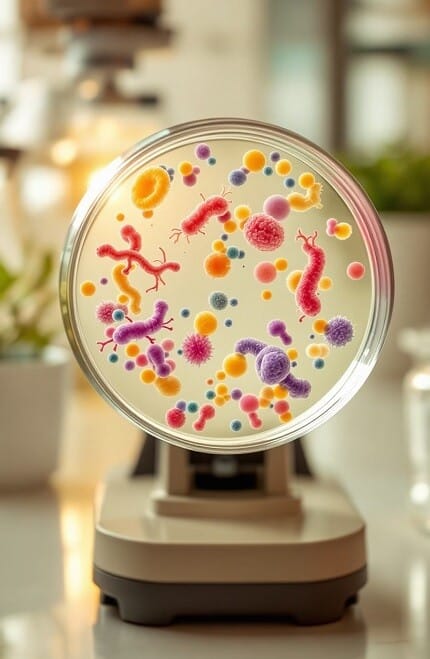
프로바이오틱스의 효능

프로바이오틱스와 피부 건강: 피부 트러블에 도움이 될까?
최근 건강 및 미용 업계에서 프로바이오틱스가 주목받고 있습니다. 프로바이오틱스는 장…

최근 건강 및 미용 업계에서 프로바이오틱스가 주목받고 있습니다. 프로바이오틱스는 장…

프로바이오틱스 복합제의 장점 : 현대인들은 건강 관리를 위해 다양한 보충제를…

장 건강이 면역력에 중요한 영향을 준다는 사실을 알고 계셨나요? 건강한…

프로바이오틱스는 장 건강을 촉진하고 면역력을 강화하는 데 중요한 역할을 합니다….
장 건강과 면역력 강화를 위한 필수 아이템인 프로바이오틱스! 오늘날 많은…

다이어트를 시작했지만 꾸준히 이어가기가 쉽지 않은 분들을 위해 다이어트에 도움이…

건강기능식품에 대한 관심이 최근 몇 년간 급증하면서, 여러 가지 제품들이…